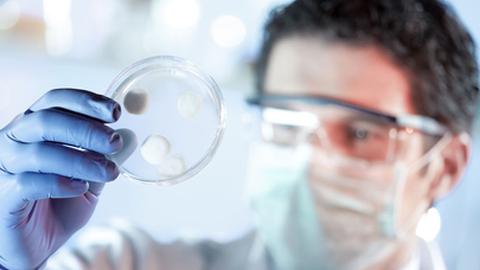
None

Voluntários do Funchal podem contribuir para estudo nacional sobre covid-19
Para este estudo nacional sobre o vírus eram necessários 215 voluntários da Madeira; neste momento ainda há vagas para a faixa etária abaixo dos 18 anos

O Painel Serológico Nacional Covid-19, promovido pelo Instituto de Medicina Molecular, com o financiamento da Sociedade Francisco Manuel dos Santos e do Grupo Jerónimo Martins, ainda tem vagas em 36 municípios, um dos quais na Madeira, para voluntários que queiram fazer teste serológico gratuito e contribuir para um estudo nacional sobre o vírus.
Para este estudo, eram necessários 215 voluntários da Madeira, do município do Funchal. Neste momento ainda há vagas para a faixa etária abaixo dos 18 anos. Para as restantes faixas etárias, a amostra na Madeira ficou completa em menos de uma semana.
Este será o primeiro painel serológico para a covid-19 de cobertura nacional alargada, que permitirá dotar Portugal da mais completa avaliação já realizada sobre a prevalência da infecção no país.
"Seis meses após o início da pandemia, é agora crítico conhecer o retrato da covid-19 que permitirá ajudar o país a equilibrar os esforços necessários à retoma social e económica com a protecção da vida".
O objectivo do estudo é determinar a proporção da população portuguesa que desenvolveu anticorpos contra o vírus SARS-CoV-2, permitindo estimar a prevalência da infecção, através da realização de testes serológicos gratuitos, nos postos do Centro de Medicina Laboratorial Germano de Sousa, empresa parceira deste projecto, a uma amostra de 12 mil voluntários, distribuídos pelas diferentes regiões e grupos etários.